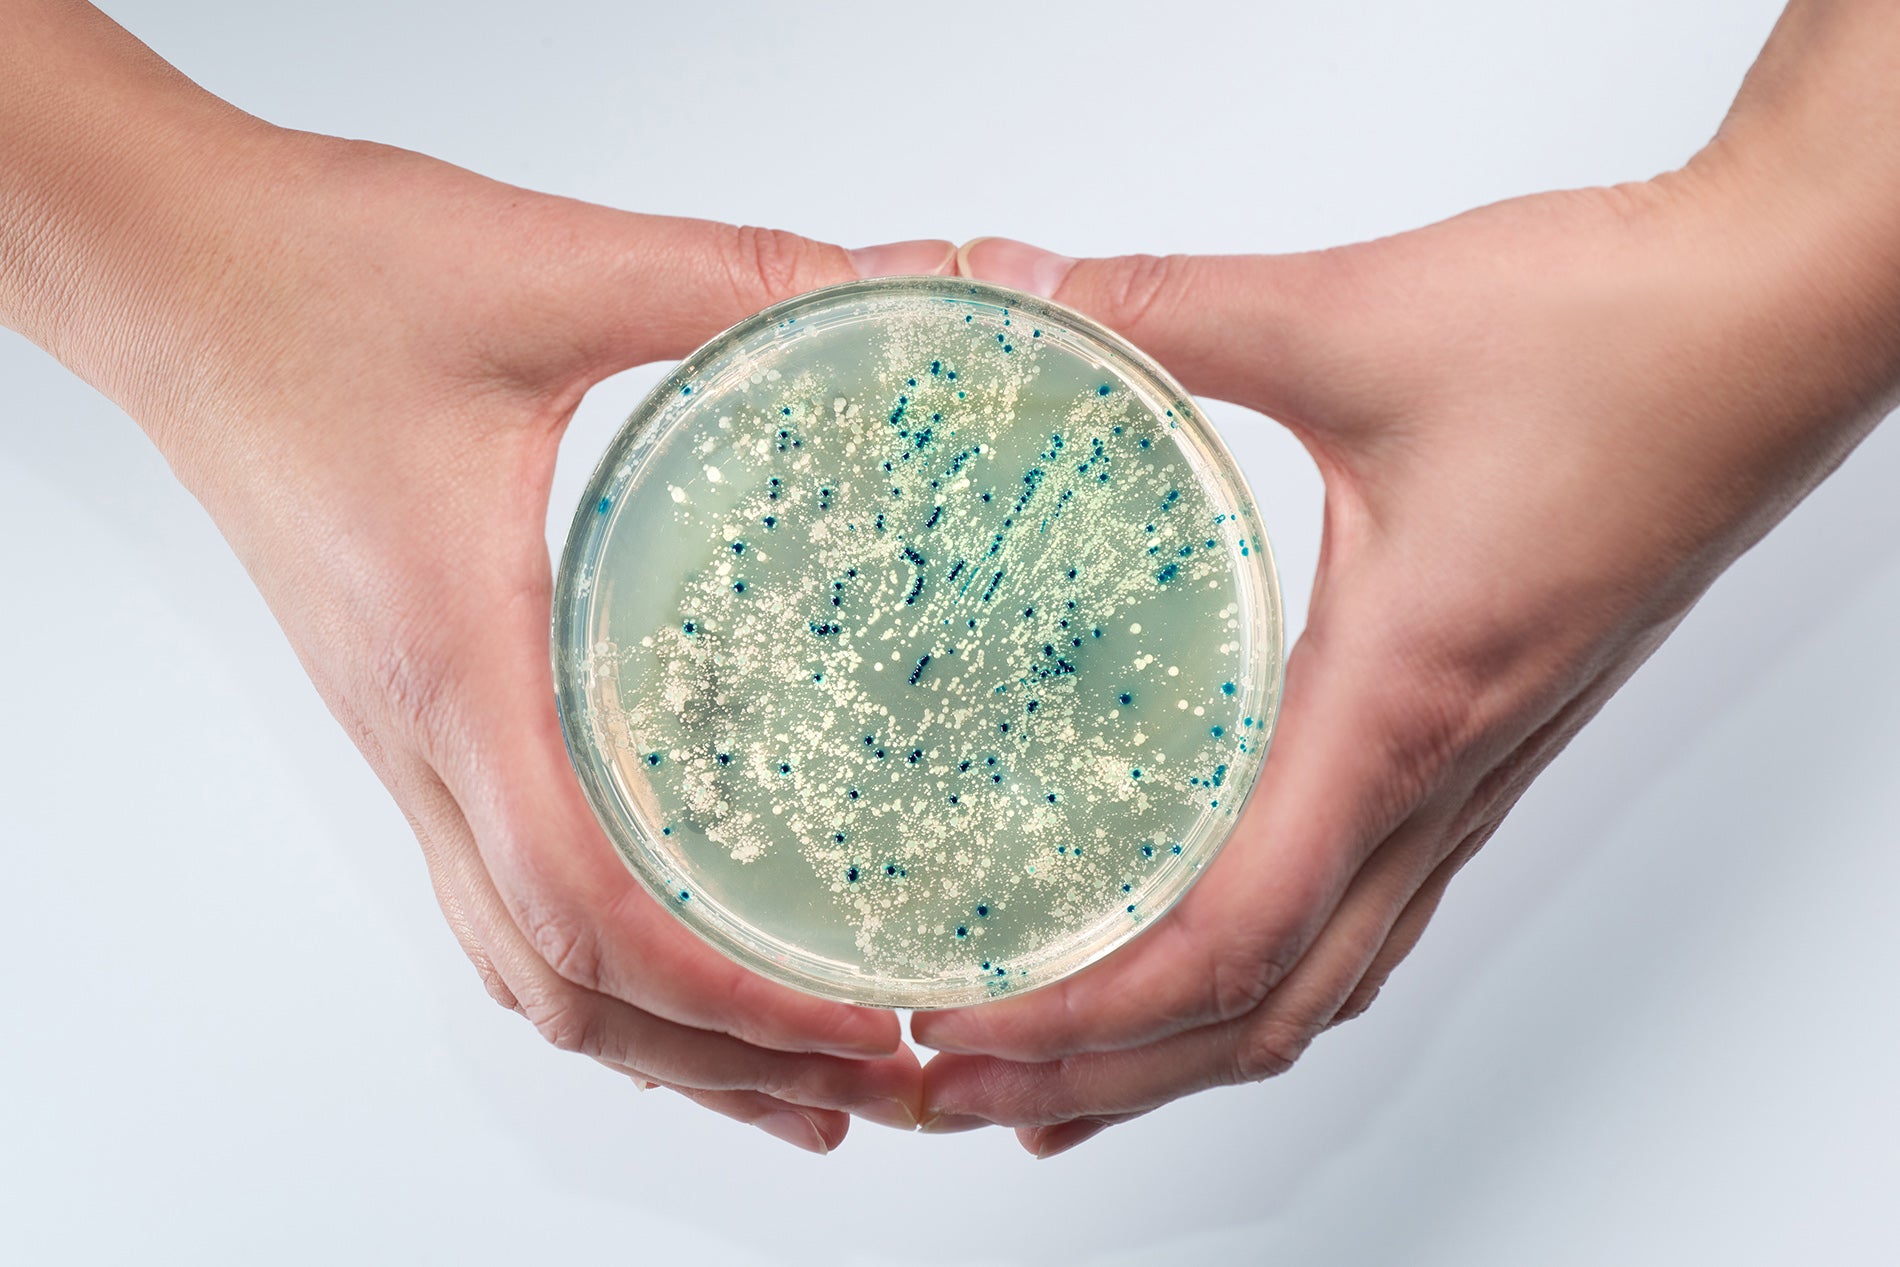
Efficacy of Electrolyzed Oxidizing Water for Inactivating Escherichia coli O157:H7, Salmonella enteritidis, and Listeria monocytogenes

HOCl Publications

Inactivation of Prions and Amyloid Seeds with Hypochlorous Acid
PLOS Pathogens: Here we show that hypochlorous acid, a disinfectant that is produced naturally by certain cells within the body, has strong anti-prion and anti-amyloid activity. We find that a non-...
Read more
As a sanitizing agent, the main “ingredient” behind the germ-killing effect of modern activated water devices is electroporation. This is a scientific process that applies a low-level electrical fi...
Read more
Hypochlorous Acid as a Potential Wound Care Agent
HOCl is known to be the major strong oxidant produced by neutrophils, and is a potent microbicidal agent within these cells. Experimentally, it has been estimated that neutrophils stimulated in vit...
Read more
American Society for MicrobiologySeptember, 1999AbstractThe efficacy of electrolyzed oxidizing water for inactivating Escherichia coli O157:H7, Salmonella enteritidis, and Listeria monocytogenes wa...
Read more